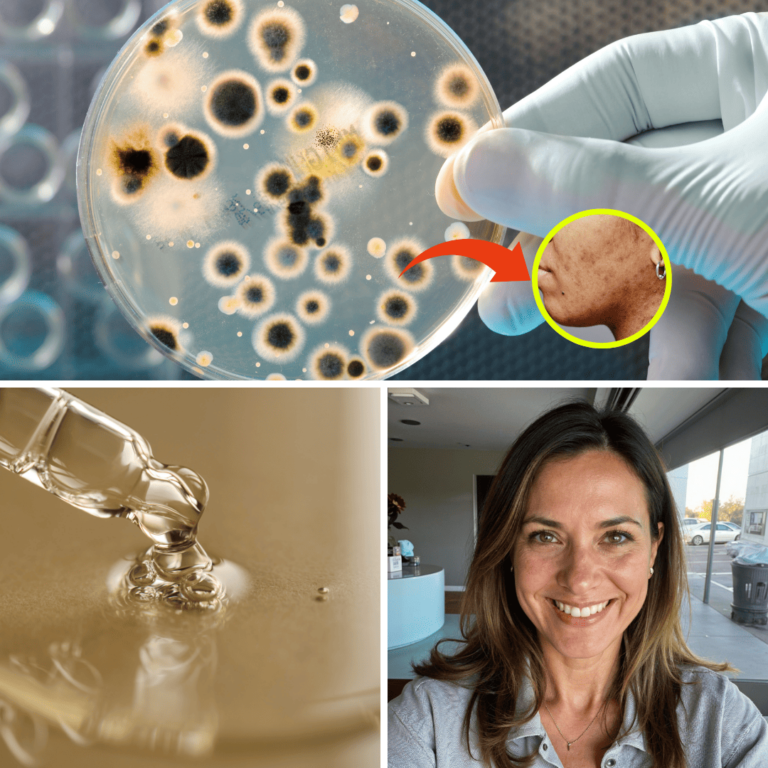

Cómo una madre ejecutiva de Medellín descubrió el secreto científico que está haciendo desaparecer las manchas rebeldes en mujeres mayores de 40

Por María Isabel Restrepo
Medellín, Colombia
"A los 48 años, mis manchas comenzaron a desaparecer como si nunca hubieran existido. Las personas me preguntan constantemente qué me he hecho en la piel"
La mayoría de las mujeres mayores de 40 no saben esto…
Pero hay una razón científica por la que las manchas en tu rostro se vuelven más oscuras y persistentes con el paso del tiempo…
Y no tiene nada que ver con el sol, el estrés o las hormonas como siempre nos han dicho…
Se trata de una enzima llamada “tirosinasa” que se vuelve hiperactiva después de los 40, produciendo manchas oscuras que parecen imposibles de eliminar.

Es posible que hayas experimentado alguna de estas situaciones…
“Cada vez uso más maquillaje para cubrir las manchas”
“Me da vergüenza tomarme fotos”
“He gastado fortunas en tratamientos que no funcionan”
Puede ser increíblemente frustrante y afectar nuestra confianza…
Afortunadamente, un descubrimiento revolucionario está cambiando la vida de cientos de mujeres…
Está haciendo desaparecer las
manchas más rebeldes en tiempo récord…
“Todo comenzó cuando me di cuenta de que estaba evitando las reuniones sociales y las fotos familiares”.
Las manchas en mi rostro se habían vuelto tan notorias que ni el mejor maquillaje podía disimularlas.
Como ejecutiva de una empresa importante, sentía que mi imagen no proyectaba la seguridad que necesitaba.
Había probado de todo: cremas carísimas, tratamientos láser, peelings químicos… incluso remedios caseros que me recomendaban las amigas. Nada funcionaba a largo plazo. Las manchas siempre regresaban, cada vez más oscuras y difíciles de tratar.

La gota que colmó el vaso fue cuando mi hija me mostró una foto familiar y me vi… apenas me reconocía.
Mi rostro estaba lleno de manchas irregulares
y un tono amarillento que me hacía parecer cansada y mucho mayor de lo que soy.
Fue entonces cuando descubrí el BIOSÉRUM MAGISTRAL.
Todo se reduce a su ingrediente estrella: la Arbutina Natural extraída de la uva ursi, que ha demostrado científicamente su capacidad para “APAGAR” la enzima tirosinasa hiperactiva.

Al principio estaba escéptica – después de tantos productos fallidos, ¿qué podría ser diferente esta vez?
Pero el Biosérum Magistral tenía algo especial: no solo prometía eliminar las manchas, sino que explicaba científicamente CÓMO lo hacía, atacando directamente la causa raíz: la tirosinasa descontrolada.
¡Los resultados me dejaron sin palabras! En solo 4 semanas, las manchas comenzaron a desvanecerse y mi piel recuperó su luminosidad natural.
Mi hija fue la primera en notarlo. ‘¡Mamá, tu piel se ve increíble!’, me dijo un día durante el almuerzo.

Incluso mis compañeras de trabajo comenzaron a preguntarme “qué me había hecho en el rostro.”
A diferencia de las cremas comunes o los tratamientos invasivos, el Biosérum Magistral trabaja de una forma completamente diferente…
Miles de mujeres ya están usando el Biosérum Magistral para decir adiós a las manchas rebeldes y recuperar su piel radiante…
Sandra P.
★★★★★
Bogotá
“Después de 2 embarazos y años de melasma, pensé que tendría que vivir con las manchas para siempre. Este sérum cambió todo. En 8 semanas mi piel se ve uniforme y luminosa. ¡Ya no necesito usar tanto maquillaje!”

Muchas mujeres notan una “mejoría visible” en tan solo 15 días…
La fórmula única del Biosérum Magistral tiene propiedades de “acción progresiva”, lo que significa que comienza a trabajar desde la primera aplicación. Algunas usuarias reportan ver mejoras notables en la primera semana.
Por supuesto, cada piel es única. Algunas personas pueden necesitar usarlo durante más tiempo para ver resultados óptimos.
Pero la mayoría de las usuarias pueden ver cómo sus manchas comienzan a desvanecerse y su piel se vuelve más uniforme en menos de 5 semanas.
Ha sido validado científicamente
Para el desarrollo del Biosérum Magistral no solo se usó uva ursi, se usaron 2 ingredientes que quizás conoces:
La Niacinamida (Vitamina B3): Numerosos estudios dermatológicos han demostrado que la niacinamida es eficaz para reducir la hiperpigmentación lo que ayuda a atenuar las manchas y unificar el tono de la piel.
y el Aloe Vera: ha sido ampliamente estudiado en el ámbito académico y clínico. Por ejemplo, investigaciones realizadas en instituciones como la Pontificia Universidad Javeriana han evidenciado que el Aloe vera posee propiedades antiinflamatorias, cicatrizantes y despigmentantes.
Es por eso que el Biosérum Magistral está científicamente respaldado y es usado diariamente por mujeres ejecutivas, empresarias y profesionales que necesitan verse y sentirse seguras, sin tener que recurrir a tratamientos agresivos o costosos.
Decidimos probarlo nosotros mismos.
¿Es todo publicidad?
Con tantos testimonios positivos y validación científica, queríamos verificar si el Biosérum Magistral realmente cumplía sus promesas.
Varias mujeres en nuestra redacción se ofrecieron como voluntarias, pero elegimos a nuestra editora de belleza, Carolina, de 45 años, quien había estado luchando con manchas persistentes durante años.
A continuación se muestra su experiencia usando el Biosérum Magistral durante un período de 4 semanas.
Semana 1:
Después de ver tantos comentarios positivos sobre este sérum, decidí probarlo yo misma. Como periodista de belleza, he probado cientos de productos antimanchas, así que mi escepticismo era alto.
La primera sorpresa fue la textura: ligera y de rápida absorción. Apliqué 3 gotas en la mañana y 3 en la noche, como indicaban las instrucciones. Para el tercer día, noté que mi piel se veía más luminosa. Las manchas más claras comenzaban a desvanecerse sutilmente. Lo más importante: no experimenté ninguna irritación, algo común con otros productos despigmentantes.
Semana 2:
Muchos productos antimanchas que he probado funcionan la primera semana y luego dejan de hacer efecto. Me preocupaba que este sérum fuera igual, pero me equivoqué. Las manchas más superficiales continuaron aclarándose, y lo que más me impresionó fue cómo el tono general de mi piel se volvió más uniforme. Incluso mi madre notó la diferencia durante nuestra videollamada semanal. Por primera vez en años, me atreví a salir sin base de maquillaje.
Semana 3:
¡Los resultados siguen sorprendiéndome! Las manchas más profundas, esas que tenía desde mis embarazos, comenzaron a aclararse notablemente. Mi piel no solo se ve más clara, sino que también se siente más firme y elástica. Una compañera del trabajo “me preguntó si me había hecho algún tratamiento láser”, ¡no podía creer que solo estaba usando un sérum!

Lo más impresionante es que, a diferencia de otros tratamientos que me dejaban la piel sensible e irritada, con este sérum mi piel se siente calmada y saludable. La fórmula realmente cumple su promesa de ser suave pero efectiva.
Semana 4:
¡Estoy asombrada con la transformación! Las manchas que me acompañaron durante años han disminuido dramáticamente. El tono amarillento desapareció por completo, y mi piel tiene un brillo saludable que no veía desde hace décadas.
Mi esposo dice que me veo radiante, y mis hijas quieren probar el sérum ellas mismas (¡aunque son demasiado jóvenes para necesitarlo!).
Lo más importante es cómo me siento: segura, rejuvenecida y lista para tomarme todas las selfies que quiera.

En conclusión:
Como editora de belleza, he probado cientos de productos “milagrosos” para las manchas. La mayoría prometen mucho y entregan poco. El Biosérum Magistral es diferente: La ciencia detrás de sus ingredientes es sólida, y los resultados hablan por sí mismos.
No es magia: es el poder de la arbutina trabajando directamente sobre la enzima tirosinasa, la verdadera causa de las manchas rebeldes. Los resultados son graduales pero consistentes, y lo mejor es que mejoran con el tiempo.
La transformación no es solo física. Hay algo increíblemente liberador en poder salir sin capas de maquillaje, en no tener que editar las fotos antes de compartirlas, en sentirse segura bajo cualquier luz.
¿Estás lista para descubrir si esto puede funcionar para ti? ¡Sigue leyendo para descubrir una oferta especial!
Considerando que gasté miles en tratamientos láser y cremas costosas que no funcionaron, el Biosérum Magistral es una inversión inteligente en mi piel y mi confianza.
Pero no confíes solo en mi palabra. Pruébalo tú misma y descubre por qué miles de mujeres están llamando a este sérum…
“El secreto mejor guardado para una piel radiante”.

Para celebrar el lanzamiento de este revolucionario sérum, la empresa está ofreciendo un 50% DE DESCUENTO especial para nuestras lectoras:
Además, todas las compras incluyen:
– Envío GRATIS a todo el país
– Pago contraentrega
Y te cuento que una vez que experimentes la transformación radical que el Biosérum Magistral ofrece a tu piel, subirás de nivel frente a otras madres y profesionales que están en tu misma situación.
ACTUALIZACIÓN: Después de publicar esta historia, el Biosérum Magistral, ha recibido una gran cantidad de pedidos y ha tenido dificultades para satisfacer la demanda. Encontramos un sitio web que todavía puede suministra el producto, al que puedes acceder aquí. Le recomiendo haga todos los pedidos que pueda para evitar que se queden sin existencias.









*Los resultados pueden variar de una persona a otra. Las imágenes y testimonios presentados reflejan experiencias individuales. Este articulo no reemplaza la opinión profesional.